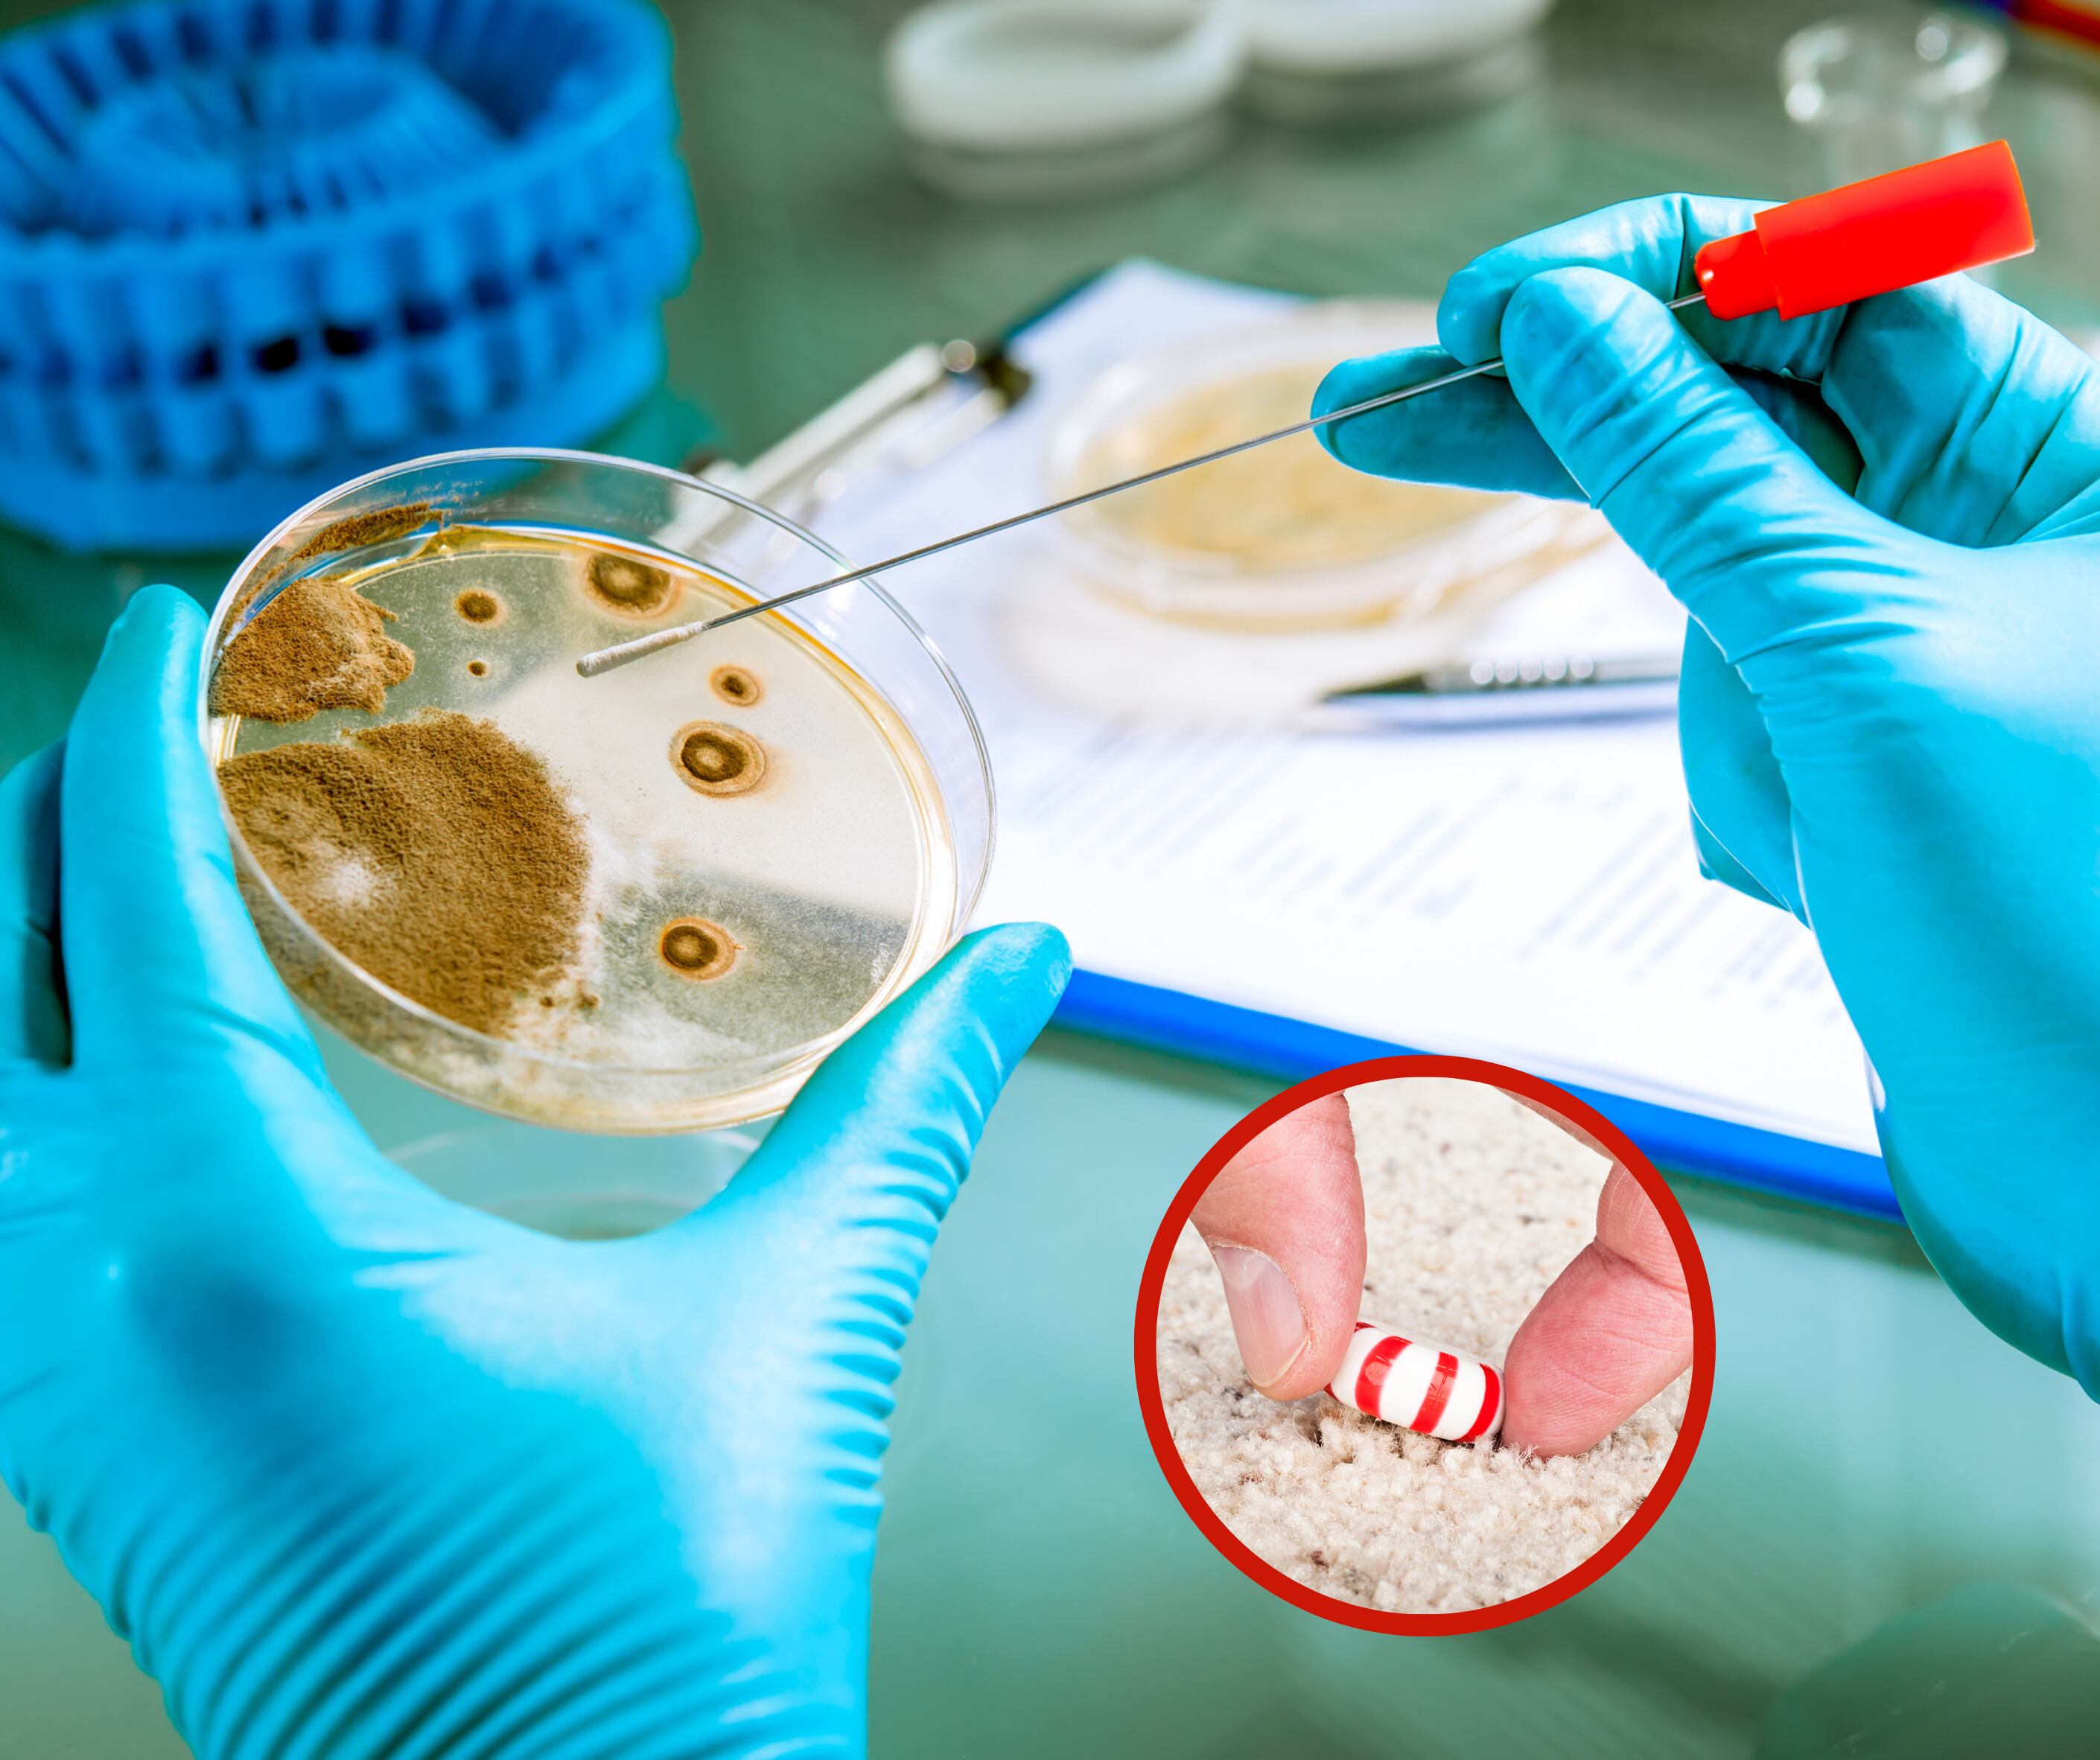
Cultivo de bacterias junto a una persona que está recogiendo un dulce de una alfombra (Fotos vía Getty Images)

¿La regla de los 5 segundos es cierta? La ciencia reveló la verdad de este mito
Aquí le explicamos que es lo que ocurre con los alimentos cada vez que caen sobre una superficie y luego son ingeridos.

Cultivo de bacterias junto a una persona que está recogiendo un dulce de una alfombra (Fotos vía Getty Images)
Esta regla es un concepto que se refiere a la idea de que, si alguien deja caer comida al suelo y la recoge en menos de 5 segundos, no se habrá contaminado con bacterias u otros gérmenes. Algunas personas creen en esta regla, pero en realidad, la cantidad de tiempo que la comida pasa en el suelo no es el único factor para considerar en términos de seguridad alimentaria.
Más información
Este ha sido un tema de debate para muchas personas a lo largo de su vida, que también ha sido estudiado por varios científicos e interesados, dando como resultado unas conclusiones llamativas.
¿La regla de los 5 segundos es cierta?
En 2007, el científico Paul Dawson y su equipo de la Universidad de Clemson llevaron a cabo un experimento para investigar la validez de la regla de los 5 segundos y lo que descubrieron fue que la cantidad de tiempo que la comida pasa en el suelo afecta la transferencia de bacterias, pero no es el único factor determinante.
En su estudio, Dawson encontró que la transferencia de bacterias ocurre casi instantáneamente al entrar en contacto con superficies contaminadas. Pero también llegaron a la conclusión de que, factores como la humedad, la textura de la comida y la superficie en cuestión también influyen en la transferencia de bacterias.
Es decir, alimentos húmedos como la sandia pueden recoger más bacterias que un alimento seco. Asimismo, durante el estudio evidenciaron que las superficies alfombradas transferían menos bacterias que aquellas superficies de baldosa o acero inoxidable.
¿Se puede comer algo que ha caído al suelo?
Como se mencionaba, eso depende de la superficie en cuestión, según Dawson casi nadie querría comer un trozo de un alimento que cayó en el suelo de un hospital o en el suelo de una cocina donde había jugo de pollo que podría causar salmonela.
Asimismo, este científico explicó que en la mayoría de los casos comer un alimento que se cayó no debería significar peligro inminente, siempre y cuando la persona también tenga un sistema inmunológico fuerte y se tengan en cuenta los aspectos mencionados.
Otra investigación
Respecto al tema, en 2003, se publicó un informe a cargo de una pasante de la Universidad de Illinois, llamada Jillian Clarke, donde se descubrió que al menos el 70% de las mujeres y un poco más de la mitad de los hombres conocen esta regla y que la mayoría de ellos la usa cuando se trata de tomar una decisión acerca de un dulce o golosina.
Asimismo, indicaron que “las mujeres son más propensas a recoger alimentos del suelo que los hombres” y que las “golosinas como dulces y galletas tienen más probabilidad de ser recogidos que alimentos saludables como el brócoli o la coliflor”.
Finalmente, de acuerdo con un artículo de National Geographic España, podría decirse que “quizá el valor de la regla de los cinco segundos o de los tres, si se es más estricto, resida más en la psicología que en la microbiología”. Agregando que “tener esa teoría proporciona una excusa socialmente aceptable para ese comportamiento desagradable”.




